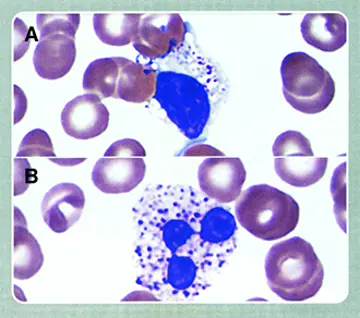

شماره ۱۰۸۶
هماتولوژی - صفحه 10
شماره ۱۰۸۵
شماره ۱۰۸۵
شماره ۱۰۸۴
شماره ۱۰۸۳
شماره ۱۰۸۲
شماره ۱۰۸۰
شماره ۱۰۷۸
شماره ۱۰۷۸